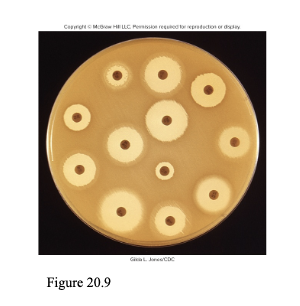
<ul><li><p style="text-align: left;"><span><span>You have some bacterial growth media in a dish and add bacteria to the surface, </span></span></p></li><li><p style="text-align: left;"><span><span>Then you add filter paper discs, and each disc has a known concentration of a different antibiotic</span></span></p></li><li><p style="text-align: left;"><span><span>Then you incubate it, and the antibiotic&nbsp;will diffuse out of the disk into the media</span></span></p></li><li><p style="text-align: left;"><span><span>Whereever the antibiotic inhibits or kills the bacteria, you will see a </span><u><span>zone of inhibition</span></u></span></p></li><li><p style="text-align: left;"><span><span>You can then measure the diameter of that zone and it will tell you if that bacteria is resistant or susceptible to the antibiotic</span></span></p></li></ul><p></p>

1/55
Looks like no tags are added yet.
Name | Mastery | Learn | Test | Matching | Spaced | Call with Kai |
|---|
No analytics yet
Send a link to your students to track their progress
Bactericidal Vs. Bacteriostatic
Bactericidal - a chemical that kills a bacteria
Bacteriostatic - a chemical that inhibits growth of a bacteria
Chemotherapeutic Agent
any type of drug used to treat any type of disease
Antimicrobial Agent
a chemical/drug that inhibits or kills microbes
Antibiotic
a type of antimicrobial agent that is naturally produced and inhibits or kills microbes
most antibiotics used clinically come from soil bacteria such as…
bacillus
streptomyces
penicillium
cephalosporium
Broad-Spectrum Antibiotic
An antibiotic that is effective against a wide range of bacteria
including both gram positive and gram negative bacteria
Narrow-Spectrum Antibiotic
An antibiotic that is effective against a limited range of bacteria
9 Features of Antimicrobial Drugs
Selective Toxicity
want antimicrobial agent to selectively kill the microorganism while doing no harm to the host
Static vs. Cidal Activity
cidal means that the antimicrobial agent kills the microbe
static means the microbe will only be inhibited from growing as long as drug is present
Spectrum of Activity
how broad or narrow of a group of microbes do you want to inhibit or kill?
a few is typically better bc some of our microbes are needed in our body, like our microbiome
Distribution
make sure antibicrobial agent reaches the infection
Metabolism and Excretion
how the body will metabolize and excrete the drug
Combinations of Antimicrobial Agents
know how the drug interacts with other drugs the patient may be taking
Adverse Effects (side effects)
Cost of Drug
Resistance
how likely is it that the drug can be inactivated or a microbe can become resistant to the drug?
Therapeutic Index
the ratio of the toxic dose of the drug versus the effective dose
want effective dose to be much less than toxic dose
Innate Resistance
Virus is naturally resistant to the drug
is not preventable
Acquired Resistance
When a microbe that is normally sensitive to an antimicrobial agent becomes resistant
What should you know about each antimicrobial agent?
Microbe it inhibits/kills
Target on the microbe
Mechanism of action
5 Targets for Antibacterial Agents
Cell Wall Synthesis
Protein Synthesis
Nucleic Acid Synthesis
Metabolic Pathways
Cell Membrane Integrity
Antibacterial Agents that Target Cell Wall Synthesis
B-lactam drugs
Vancomycin
Bacitracin
B-Lactam Drugs
Inhibit peptidoglycan synthesis by inhibiting penicillin binding proteins to prevent crosslinking of peptidoglycan polymers
They all work by inhibiting the formation of cross links
Cross links are formed by penicillin binding proteins
No cross links means weak cell wall, and the bacterial cell will lyse
Once the cross link is formed, they cant do anything, they only stop the synthesis of crosslinks
all types of B-lactam drugs share a similar structure
Square connected to a pentagon
Look like a house with a garage
square is the B-lactam ring
Includes
penicillins
or any drug that ends in -illin
cephalosporins
carbapenems
monobactams
Vancomycin
Inhibits peptidoglycan synthesis but in a different way
Binds to the end of the peptide chains coming off of NAM, preventing formation of crosslinks
Creates a weak cell wall and the cell to lyse
Found in a lot of triple antibiotic ointments
Drug of last resort to treat MRSA infections
Bacitracin
Inhibits peptidoglycan synthesis by preventing the transport of NAG and NAM to where peptidoglycan is being synthesized
How do different strains of penicillin differ from each other?
They all have the same basic structure of the B-lactam ring, but they differ in their side chains

6 Antibacterial Agents that Inhibit Bacterial Protein Synthesis
Aminoglycosides
Tetracyclines
Macrolides
Chloramphenicol
Lincosamides
Oxazolidinones
all inhibit some step in translation
Aminoglycosides
Binds to the 30S subunit on ribosome and blocks initiation of translation
if initiation still occurs, it causes misreading of mRNA, making a faulty protein
Ex)
Streptomycin
tobramycin
gentamycin
amikacin
Tetracyclines
Binds to 30s unit on ribosome
Blocks tRNA molecules from entering into the A or P site
This causes elongation to stop
Macrolides
Binds to 50S subunit to prevent translocation
ex)
Erythromycin
azithromycin
clarithromycin
Chloramphenicol
Binds to 50S subunit to prevent peptide bond formation
often used for bacterial meningitis
makes it so the ribosome cant connect amino acids
Lincosamides
Binds to 50S subunit to prevent elongation
Ex) Clindamycin
Oxazolidinones
Binds to 50S subunit to prevent initiation
ex) Linezolid
Streptogramins
Bind to 50s subunit and interferes with different steps of protein synthesis
Pleuromutilins
Binds to 50s subunit and prevent peptide bonds from being formed
Antibacterial Agents that Inhibit Nucleic Acid Synthesis
Fluoroquinolones
Rifamycins
Fluoroquinolones
Inhibits topoisomerases (DNA Gyrase)
DNA gyrase relieves the supercoiling as we unwind bacterial DNA during replication
Bacteria cant replicate DNA then bc there is so much supercoiling they cant separate their strand of DNA
Rifamycins
blocks bacterial RNA polymerase from initiating transcription
often used to treat tuberculosis
Antibacterial Agents that Inhibit Metabolic Pathways
Sulfa Drugs
Trimethoprim
*These drugs interfere with the pathway for the synthesis of folic acid
*They target a metabolic pathway unique to the bacteria
Sulfa Drugs
Some bacteria make their own folic acid using a specific metabolic pathway
One of the intermediates in this pathway is PABA, which is the first enzyme in the pathway
sulfa drugs like sulfanilamide inhibit the PABA enzyme by entering the active sight and blocking it so PABA can’t enter the pathway
Used to treat UTIS

Trimethoprim
Trimethoprim does the same thing as sulfa drugs in the folic acid metabolic pathway for bacteria, but it inhibits enzyme 3 instead of the first enzyme

Antibacterial Agents that Interfere with Cell Membrane Integrity
The bacterial cell membrane is similar in structure to human cell membranes, only difference is the charge of the lipids in the outer leaflet (bacteria outer lipids are negative, human outer lipids are neutral). This helps drugs know what to target
Types of Drugs
Polymyxin B
Daptomycin
Polymyxin B
Binds to cell membrane of Gram negative bacteria
Alters cell membrane permeability by causing it to be leaky and the cytoplasm to leak out, leading to cell death
Daptomycin
Inserts into cell membrane of Gram positive bacteria
also causes leakage of cellular contents, and then cell death
Cannot penetrate the outer membrane of Gram negative bacteria
Antibiogram
an antibiotic susceptibility profile
(tells us what antibiotics work best against a specific bacteria)
How to Determine Drug Susceptibility
Must do testing to find the antibiogram (antibiotic susceptibility profile)
Once they isolate the bacteria causing the infection, they will take that bacteria and test it against a panel of different antibiotics to see which antibiotic will be most effective
Methods to do this include:
MIC Value
Disc Diffusion / E-Tests
MIC Value
In the lab, they will determine the minimal inhibitory concentration for a group of antibiotics
They use a series of test tubes and each tube contains a dilution of a particular antibiotic
then they inject each tube with same amount of bacteria and determine what the value of the lowest amount of drug would be to eliminate the bacteria (the lowest concentration that prevents the growth of microbe)
Disc Diffusion Tests
You have some bacterial growth media in a dish and add bacteria to the surface,
Then you add filter paper discs, and each disc has a known concentration of a different antibiotic
Then you incubate it, and the antibiotic will diffuse out of the disk into the media
Whereever the antibiotic inhibits or kills the bacteria, you will see a zone of inhibition
You can then measure the diameter of that zone and it will tell you if that bacteria is resistant or susceptible to the antibiotic
E Tests
Same idea as the Disc Diffusion, but instead of filter paper discs, there is a strip of paper has a gradient of the antibiotic
the antibiotic will diffuse out into the growth media and create a zone of inhibition
The place where the zone of inhibition meets the strip at the bottom tells us the MIC number

How does mycoplasma pneumoniae exhibit characteristics of innate resistance?
mycoplasma pneumoniae (causes walking pneumonia) does not have a cell wall, so it is inherently resistance to B lactam drugs bc these drugs target peptidoglycan in cell walls
Mechanisms of Acquired Resistance
Drug-inactivating enzymes
b-lactamases
A lot of bacteria that is resistant to B lactam drugs produce B-lactamase which is an enxyme that breaks the B lactam ring
chloramphenicol acetyltransferase
Alteration of target
there is a mutation that alters the target of the drug so now the drug doesn’t bind to the target anymore
Decreased uptake of drug
due to changes in porin proteins, which affects what can get through the outer membrane
Increased elimination of drug
Efflux pumps in cell membrane that pump out drug as soon as they get inside the bacterial cell

Why is overuse of antibiotics concerning?
The more you take that antibiotic, the more you kill the susceptible bacteria and cause natural selection for resistance bacteria
Bacteria with emerging resistance:
enterococci
staphylococci
streptococci
mycobacteria
How do bacteria acquire resistance?
Spontaneous mutations
Ex) Mutation in a gene that encodes for a part of the ribosome, changing the target area for drugs so the drug cant bind
Cant do anything about it
Another ex) Aminoglycosides cause misreading of mRNA, causing mutations
Decreased uptake is a type of spontaneous mutation as well
Horizontal gene transfer
Transfer of R plasmids through conjugation or transformation
these plasmids carry genes that encode proteins that modify or destroy the antimicrobial agent
Transposons
known to carry drug inactivating enzymes
Ex) Efflux pumps
How to Slow the Spread of Antibiotic Resistance
Limit non-medical use of antibiotics
Selective and appropriate use of antibiotics
Antibiotics only effective for bacterial infections
Drug selection (choosing the correct specific drug)
Ensure dose and duration are adequate
Combination therapy
Using 2 different bacterial agents that target different things
What percentage of prescriptions given to people are given to people with viral infections instead of bacterial infections?
50%
Antiviral Agents
Very few antiviral agents
The ones that exist are for a select few viruses
For the ones out there, each antiviral agent is going to target some step in the viral replication cycle
5 Things Antiviral Agents Target in the Viral Replication Cycle
Some block entry of the virus
Some inhibit the uncoating of the virus once inside the cell
Only works against flu a, not b
Some target nucleic acid synthesis of virus
Stops it from making copies of itself
Some target genome integration
Retroviruses – have RNA that they convert into DNA, which is inserted into host genome using an enzyme called integrase
Integrase inhibitors are effective against this
Some target assembly and release of virus
Ex) Paxlovid interferes with assembly and release of virus for COVID

6 Antifungal Drugs
Polyenes
Azoles
Allylamines
Griseofulvin
Flucytosine
Tavaborole
Polyenes
Binds to ergosterol and disrupts integrity of cell membrane
When binding to ergosterol, it creates a pore in the membrane and causes leakage of cell contents
can sometimes bind to cholesterol which can be toxic
ex) Amphotericin B
Azoles
inhibit synthesis of ergosterol
Target synthesis of ergosterol by inhibiting enzymes in the pathway
If it cant make ergosterol, cell membrane doesn’t function properly, causing death of fungus
Ex) Fluconazole, itraconazole, ketoconazole
Allylamines (terbinafine)
inhibits ergosterol synthesis
Griseofulvin
inhibits tubulin polymerization
Spindle fibers used to move chromosomes during mitosis are made of tubulin, so if inhibited, you prevent mitosis or meiosis, affecting replication
Flucytosine
Gets converted to 5-fluorouracil, which inhibits the enzyme needed for nucleic acid synthesis
Tavaborole
inhibits protein synthesis by preventing the charging of tRNA’s with amino acids (cant load tRNA with amino acids)
used only for onychomycosis (fungal nail infections